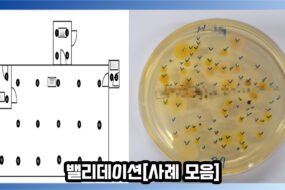

이번 납품 사례는 CAS사의 로드셀 LSS-30T와
같은 CAS사의 인디케이터 CI-501A의 연동 납품 사례입니다

이번 사례는 고중량 로드셀에 고분해능 인디케이터를
연결하여 사용한 사레로 높은 중량을 사용하고
정확한 계량이 필요한 곳에서 사용하기 위해 납품된 사례입니다

LSS-30T는 CAS사의 디스크타입 인장 압축 로드셀로
스테인레스 스틸 재질의 밀폐 구조로
IP 68등급 규격에 준하는 설계 구조를 가지고 있어
호퍼 및 탱크, 사일로 스케일 등 거친 산업에서 사용하기 적합한 제품입니다

[제품 정보]
CAS / LSS-30T / 디스크타입 로드셀

CI-501A는 CAS사의 고분해능 인디케이터입니다
RFI(전파방해)/EMI(전자방해) 차폐 기능이 있어 노이즈가 많이 발생하는
산업 환경에서 안정적으로 시스템 구동이 가능하며
터미널 블록이 적용되어 프린터, PLC, 컨트롤러와의 연결이 용이하고
시리얼 통신이 내장되어 있어 프린터 및 외부 표시기, PC와 연결하는 것이 가능합니다
[제품 정보]
CAS / CI-501A / 고분해능 인디케이터
궁금한 사항이나 솔루션이 필요하시다면
필요하신 사양과 어떤 용도로 사용하실지 확인 후
본 페이지 하단의 견적문의란에 남겨주시면 친절하게 안내해 드리겠습니다
언제나 유익한 정보 소개하는 카스스케일 코리아가 되겠습니다

No Comments